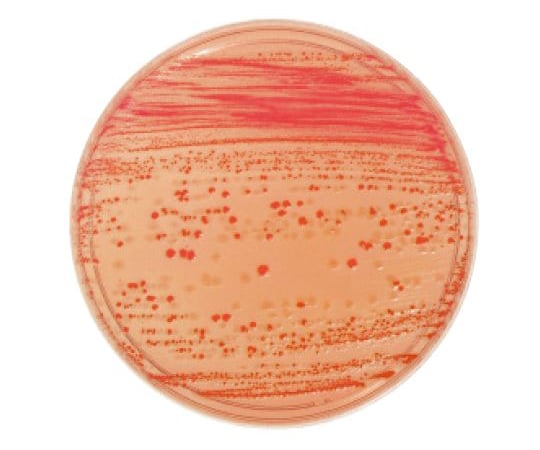
63-6527-16 BD BBL（TM） ソルビトール添加マッコンキーⅡ寒天培地 20

安い割引 BD 63-6527-16 まとめ買い用です BBL(TM) 20 ソルビトール添加マッコンキーⅡ寒天培地 掃除機・クリーナー
(3019件)
Pontaパス特典
サンキュー配送
11600円(税込)
116ポイント(1%)
Pontaパス会員ならさらに+1%ポイント還元!
送料
(
)
3002
配送情報
お届け予定日:2026.04.24 10:34までにお届け
※一部地域・離島につきましては、表示のお届け予定日期間内にお届けできない場合があります。
ロットナンバー
64512251147
お買い物の前にチェック!

Pontaパス会員なら
ポイント+1%
ポイント+1%
商品説明
まとめ買い用| カテゴリー: | 生活家電・空調>>>掃除機(キャニスター)>>>その他 |
|---|---|
| 商品の状態: | 目立った傷や汚れなし","細かな使用感・傷・汚れはあるが、目立たない |
| 配送料の負担: | 送料込み(出品者負担) |
| 配送の方法: | 佐川急便/日本郵便 |
| 発送元の地域: | 京都府 |
| 発送までの日数: | 2~3日で発送 |
レビュー
商品の評価:




 4.4点(3019件)
4.4点(3019件)
- HARU3932
- ブラックを購入しました。 つや消しな感じで思ってた通りです。 組立も簡単で作りもしっかりしてます。 全ての物がすっきり収まり持ち運びに便利です。 まさしく見せる収納ですね! 全てに満足です。
- りょん0919
- これまでは、廊下に寝せて置いていたため通行の邪魔になっていましたが、こちらを使用してからはそれが解消され大変満足しています。充電もしやすいです。
- TTTKKK6073
- 壁に穴をあけるのが嫌で立てかけていましたが、よく倒れるので困っていました。 すっきりシンプルだし、収納したまま充電もできるので便利です。もっと早く買えばよかったです。
- 購入0511
- makitaのCL182FDZWの置き方に困っていましたが、見た目も機能もコストパフォーマンスも高く大変助かりました。ストレートパイプにノズルをつけた状態だと位置を調整しないとフレーム上部に干渉しますが大した問題ではありません。スタンドがもう少し重いとより安心ですが価格からしたら贅沢は言えないかな。購入して良かったです。
- jun3359
- 安くて良いです!安定していて裏に収納できるので使いやすいです!
- ヨッチ1234
- イマイチ、付属部品の収まりが悪い。 重なり合うし、改善が必要だと思う。
- Jyoutarou
- 組み立ても簡単でとてもしっかりしています。それでいて主張しすぎずで良いと思います。
- わんにゃんハウス
- 犬を飼っているので長年の夢でした。部屋の大々的な模様替えを機にやっと購入しました。思ったより静かでとってもよくゴミを吸ってくれます。でもどこからかわかりませんが、長い自分の髪を垂らしたまましゃがんで棚の下を吸おうとしたら自分の神がモーターに絡まって焦げました。すぐに電話して一度回収して見てもらえました。対応もとても良いです。着いてきたパーツで背の高いタンスの上も掃除できて気に入っています。もう少し時間が長く使えたら最高!
- 変態親父!
- お安く購入出来て良かったです デザインも気に入っています
- 腹を割って話そう
- 主人にv10をプレゼントしてもらい、充電するのに壁に穴を開けたくないので、迷っていたらこちらの商品を見つけました。説明書にv10が書いていなかったので迷いましたが、スッキリ片付けをする事が出来良かったです!
- Pleasey
- 組み立ても簡単で、木製の別の商品と迷いましたが軽いので設置もラクでした。
- 阿波の金太郎 222
- 商品到着時、外装ダンボールに斜めに大きなガムテープが貼ってあり、不審に思って剥がしてみると、ダンボールが斜めに裂けており、中の発泡スチロールも同じように真っ二つに裂けていました。つまり、梱包時に何らかのアクシデントで割れた梱包材をそのまま使用し、それを隠すために上から応急処置でガムテープを貼り、そのまま出荷してるのです。今のご時世、こんな状態の商品を平気で市場に出してしまうメーカーが存在することに愕然としました。案の定、商品には大きな傷。年末だし、返品しても交換品が来るのは正月休み明けでだいぶ遅くなるだろうし、恐らく品質管理も品質保証も機能してない会社でしょうから、まともに返品に応じてくれそうもないのでやめました。 商品のアイデアはいいと思うだけに、非常に残念。
- 灼眼のもっかん
- 組み立て簡単。パーツも収納できてスッキリ。大変満足してます。
- まさきんぐ3930
- 山崎実業の商品は結構購入しています。 塗料もツルツルなのでよかったです。 ダイソンV8用に購入しましたが、本体、アタッチメント共にしっかり設置できました。 見た目も大変よく、リビングの隅においても違和感ありません。
すべて見る
お店の情報
7,367
連絡・応対
4.3
配送スピード
4.3
梱包
4.3